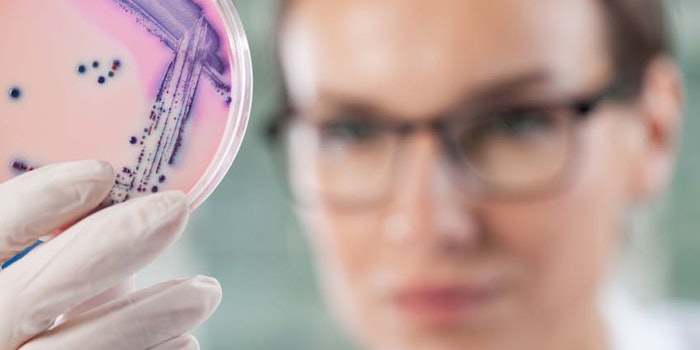

Pluralibacter gergoviae was the culprit behind the recent recall of certain lot numbers of Arbonne International's Shea Butter Body Wash, Gel Douche, the U.S. Food and Drug Administration (FDA) reports.
According to a blog post on Microbioligics, this opportunistic pathogen has repeatedly been isolated from personal care products. The California-based manufacturer was said to identified its presence during product testing. The recall was specific to 3,100 units sold in 16 oz/473 mL plastic dispensers; lot numbers: 9107A05, 9108A05.
This recall follows prior recalls by the company in 2016 for 3,818 units of its Eclipse (black) and Arbor (brown) liquid eyeliner, which were found to be contaminated by Staphylococcus saprophyticus, Staphylococcus lentus and Staphylococcus xylosis, the FDA reported. These recalls were specific to lot numbers: 0206, 0216, 0256, 0256 (a), 0266, 1266, 3565, 3575 and 1196; and 3535 and 3555 for black and brown, respectively.
Furthermore, an October 11, 2017, story in Health News reported the company recalled its Rescue & Renew Detox Body Wash due to the presence of Staphylococcus cohnii; another reportedly pathogenic bacteria that lives on the skin. The report stated the product was, "infused with aromatic essential oils and skin-conditioning agents that help improve skin tone with every wash."
These incidents are sobering reminders of the importance of preservative efficacy testing; for a refresher, see Steinberg and Orth's 2009 paper.